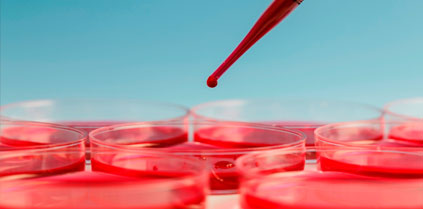

Les bébés qui démarrent la diversification alimentaire trop tard auraient un risque accru de leucémie aiguë lymphoblastique, une forme de leucémie qui touche surtout les enfants.
Selon une nouvelle étude présentée cette semaine lors du congrès de l’Association américaine pour la recherche sur le cancer, l’âge auquel on introduit les divers aliments solides dans l’alimentation du bébé serait particulièrement important. En effet, une diversification alimentaire trop tardive augmenterait le risque de leucémie aiguë lymphoblastique, une forme de leucémie qui touche surtout les enfants et qui apparaît soudainement, avec seulement quelques jours ou quelques semaines entre les premiers symptômes et le diagnostic.
Pour cette étude, les chercheurs américains ont suivi 172 enfants originaires du Texas, atteints par cette forme de leucémie et 344 enfants du même âge et ne souffrant d’aucune maladie. Certains d’entre eux avaient été allaités au sein, d’autres au biberon, avant l’introduction de l’alimentation solide. Ils se sont alors aperçus que les enfants qui avaient démarré la diversification alimentaire tardivement (c’est-à-dire après l’âge de 10 mois) avaient quatre fois plus de risque d’être touchés par la leucémie aiguë lymphoblastique, que les bébés qui démarraient la diversification alimentaire à 4 mois. Selon les chercheurs, ce risque est multiplié par trois lorsque la diversification démarre entre 7 et 9 mois, en revanche, il n’y a aucun risque accru lorsqu’elle démarre entre 5 et 6 mois.
La leucémie aiguë lymphoblastique est liée à la multiplication incontrôlée de certains globules blancs (les lymphoblastes) qui envahissent la moelle osseuse. Celle-ci ne peut alors plus fonctionner correctement et, notamment, assurer la production des cellules sanguines normales. C’est une maladie qui touche essentiellement les enfants de moins de 5 ans mais qui reste rare : on compte moins de 300 nouveaux cas chaque année en France.
Top Santé